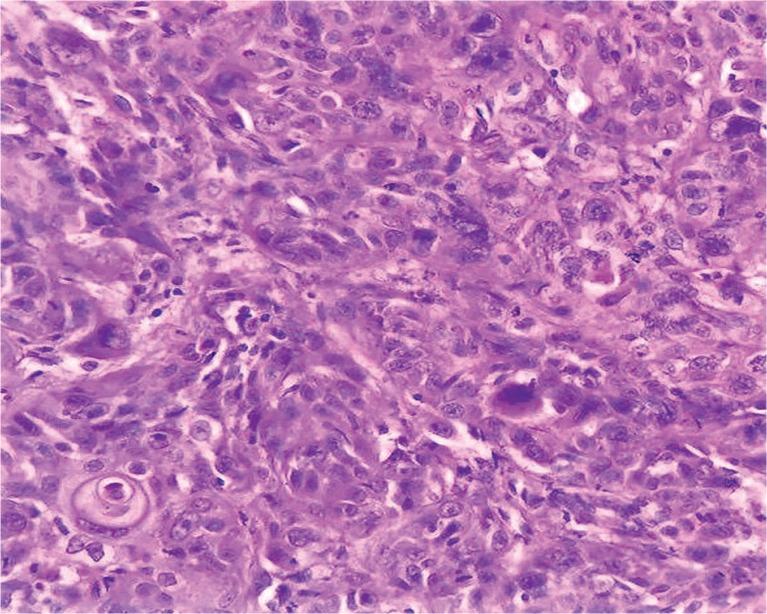
https://cdn.ncbi.nlm.nih.gov/pmc/blobs/2817/6107092/0875c0aa1858/MR-17-77304-g002.jpg

卵巢成熟性囊性畸胎瘤的恶性转化:8例回顾性研究及文献复习
Malignant transformation in mature cystic teratoma of the ovary: a retrospective study of eight cases and review of literature.
作者信息
Rathore Ruchi, Sharma Sonal, Agarwal Sarla
机构信息
University College of Medical Sciences, New Delhi, India.
North Delhi Municipal Corporation Medical College and Hindu Rao Hospital, New Delhi, India.
出版信息
Prz Menopauzalny. 2018 Jun;17(2):63-68. doi: 10.5114/pm.2018.77304. Epub 2018 Jun 30.
INTRODUCTION
Mature cystic teratoma (MCT) is the most common type of ovarian germ cell neoplasm, but occasionally it may undergo malignant change in any one of its elements. In this study, these rarely encountered tumors, occurring over a period of 25 years, were studied.
MATERIAL AND METHODS
A retrospective, tertiary hospital-based study was carried out in all histopathologically diagnosed cases of MCT (230) of the ovary from January 1990 to December 2014. The clinicopathological features of malignant transformation (MT) in MCT of the ovary were retrieved from the archives of the Department of Pathology and were analyzed.
RESULTS
Two hundred thirty (230) mature cystic teratomas of the ovary were found. MT was noted in eight of these cases, i.e. 3.5% of all the MCT. The mean age of the patients with MCT was 32.5 ±13.11 while the mean age of the patients with malignant transformation in MCT was 44.2 ±8.94 years. Grossly the mean size of the malignant teratoma was 11.7 ±2.7 cm, whereas it was 7.6 ±2.1 cm for mature cystic teratoma. Squamous cell carcinoma (SCC) was the most frequent MT seen in four out of eight cases, while one case showed an adenocarcinoma and the other a malignant melanoma, and two cases had transitional cell carcinoma.
CONCLUSIONS
The rate of malignant transformation in MCT increases with age and is much higher in the postmenopausal age group. Moreover, although SCC is still the commonest, transitional cell carcinoma (TCC) may also develop not infrequently as malignancy apart from other rare differentiations such as adenocarcinoma or malignant melanoma in an MCT.
引言
成熟囊性畸胎瘤(MCT)是卵巢生殖细胞肿瘤最常见的类型,但偶尔其任何一个成分都可能发生恶变。在本研究中,对25年间出现的这些罕见肿瘤进行了研究。
材料与方法
对1990年1月至2014年12月期间所有经组织病理学诊断为卵巢MCT(230例)的病例进行了一项基于三级医院的回顾性研究。从病理科档案中检索卵巢MCT恶变(MT)的临床病理特征并进行分析。
结果
共发现230例卵巢成熟囊性畸胎瘤。其中8例出现MT,即占所有MCT的3.5%。MCT患者的平均年龄为32.5±13.11岁,而MCT发生恶变患者的平均年龄为44.2±8.94岁。大体上,恶性畸胎瘤的平均大小为11.7±2.7cm,而成熟囊性畸胎瘤为7.6±2.1cm。鳞状细胞癌(SCC)是8例中4例最常见的MT类型,1例为腺癌,1例为恶性黑色素瘤,2例为移行细胞癌。
结论
MCT的恶变率随年龄增加而升高,在绝经后年龄组中更高。此外,虽然SCC仍然是最常见的,但除了MCT中腺癌或恶性黑色素瘤等其他罕见分化类型外,移行细胞癌(TCC)作为恶性肿瘤也可能并不少见地发生。